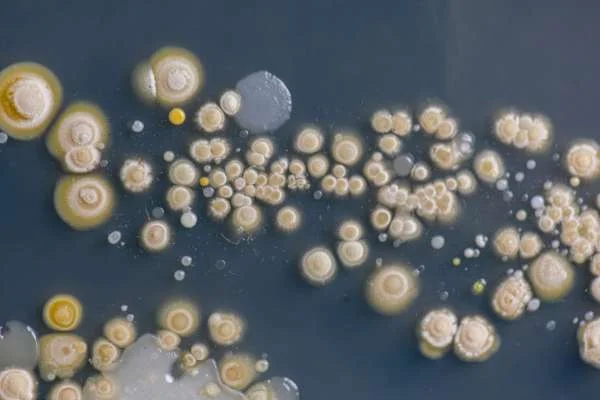
Tối Ưu Hóa Sản Xuất Giống Cá Tra Bằng Công Nghệ Vi Sinh

Ương Cá Nâu Giống: Sự Quan Trọng và Chi Tiết
1. về Ương Cá Nâu
Ương cá nâu (Lates calcarifer), còn được gọi là cá cơm, là một loại cá biển nước ngọt có giá trị kinh tế cao. Đây là một loài cá mang tính biểu tượng ở nhiều khu vực trên thế giới, đặc biệt là ở khu vực Đông Nam Á và Úc.
2. Quá Trình Sinh Sản
Thuần Chủng: Quá trình chọn lựa thuần chủng (bằng phương pháp lai tạo) giữa những cá cái và cá đực có phẩm chất tốt nhất là bước quan trọng để tạo ra Ương Cá Nâu Giống chất lượng.
Yếu Tố Môi Trường: Sự ổn định môi trường nuôi và chăm sóc cá trong quá trình sinh sản là yếu tố quyết định thành công của việc nuôi Ương Cá Nâu Giống.
3. Kỹ Thuật Nhân Giống
Thu Thập Trứng: Quá trình thu thập trứng từ cá cái sau khi chúng đẻ là bước đầu tiên trong quá trình nhân giống. Trứng được thu thập một cách cẩn thận để đảm bảo chất lượng.
Tinh Trùng: Tinh trùng từ cá đực cũng được thu thập và xử lý để sử dụng trong quá trình thụ tinh nhân tạo.
Thụ Tinh Nhân Tạo: Thụ tinh nhân tạo là kỹ thuật phổ biến được sử dụng để kết hợp trứng và tinh trùng trong một môi trường kiểm soát để tạo ra ươm trứng.
4. Quản Lý Ương Cá Nâu Giống
Điều Kiện Nuôi: Quản lý điều kiện nuôi trong các hệ thống ươm trứng là cực kỳ quan trọng. Điều chỉnh nhiệt độ, ánh sáng, và chất lượng nước là chìa khóa để đảm bảo sự phát triển khỏe mạnh của trứng và ươm.
Điều Kiện Dinh Dưỡng: Cung cấp dinh dưỡng đúng đắn cho các ươm trứng là quan trọng để tăng cường sức khỏe và tăng trưởng của ươm cá.
5. Giải Pháp Kỹ Thuật
Sử Dụng Hormon: Sử dụng hormone sinh sản có thể được áp dụng để kích thích sinh sản và tăng tỷ lệ đậu trứng trong quá trình nhân giống.
Sử Dụng Công Nghệ: Công nghệ tiên tiến như hệ thống lọc nước tự động, kiểm soát nhiệt độ tự động và hệ thống quản lý thông tin có thể được tích hợp để tăng hiệu suất và giảm thiểu rủi ro trong quá trình nuôi ươm.
6. Ứng Dụng Trong Ngành Thủy Sản
Nguồn Gốc Cá Cơm Chất Lượng Cao: Ương Cá Nâu Giống được nuôi ươm chất lượng cao có thể được sử dụng để cải thiện nguồn cá thương phẩm trong ngành thủy sản.
Cải Thiện Năng Suất: Sử dụng Ương Cá Nâu Giống chất lượng cao có thể tăng cường năng suất và lợi nhuận cho các trang trại cá nuôi.
7. Thách Thức và Triển Vọng
Thách Thức Về Môi Trường: Sự biến đổi khí hậu và ô nhiễm môi trường là những thách thức lớn đối với quá trình nhân giống và nuôi ươm Ương Cá Nâu Giống.
Triển Vọng Trong Phát Triển Kinh Tế: Với nhu cầu ngày càng tăng về sản phẩm cá, việc phát triển quy trình nhân giống hiệu quả và bền vững có thể mang lại triển vọng kinh tế lớn cho ngành nuôi cá thương phẩm.